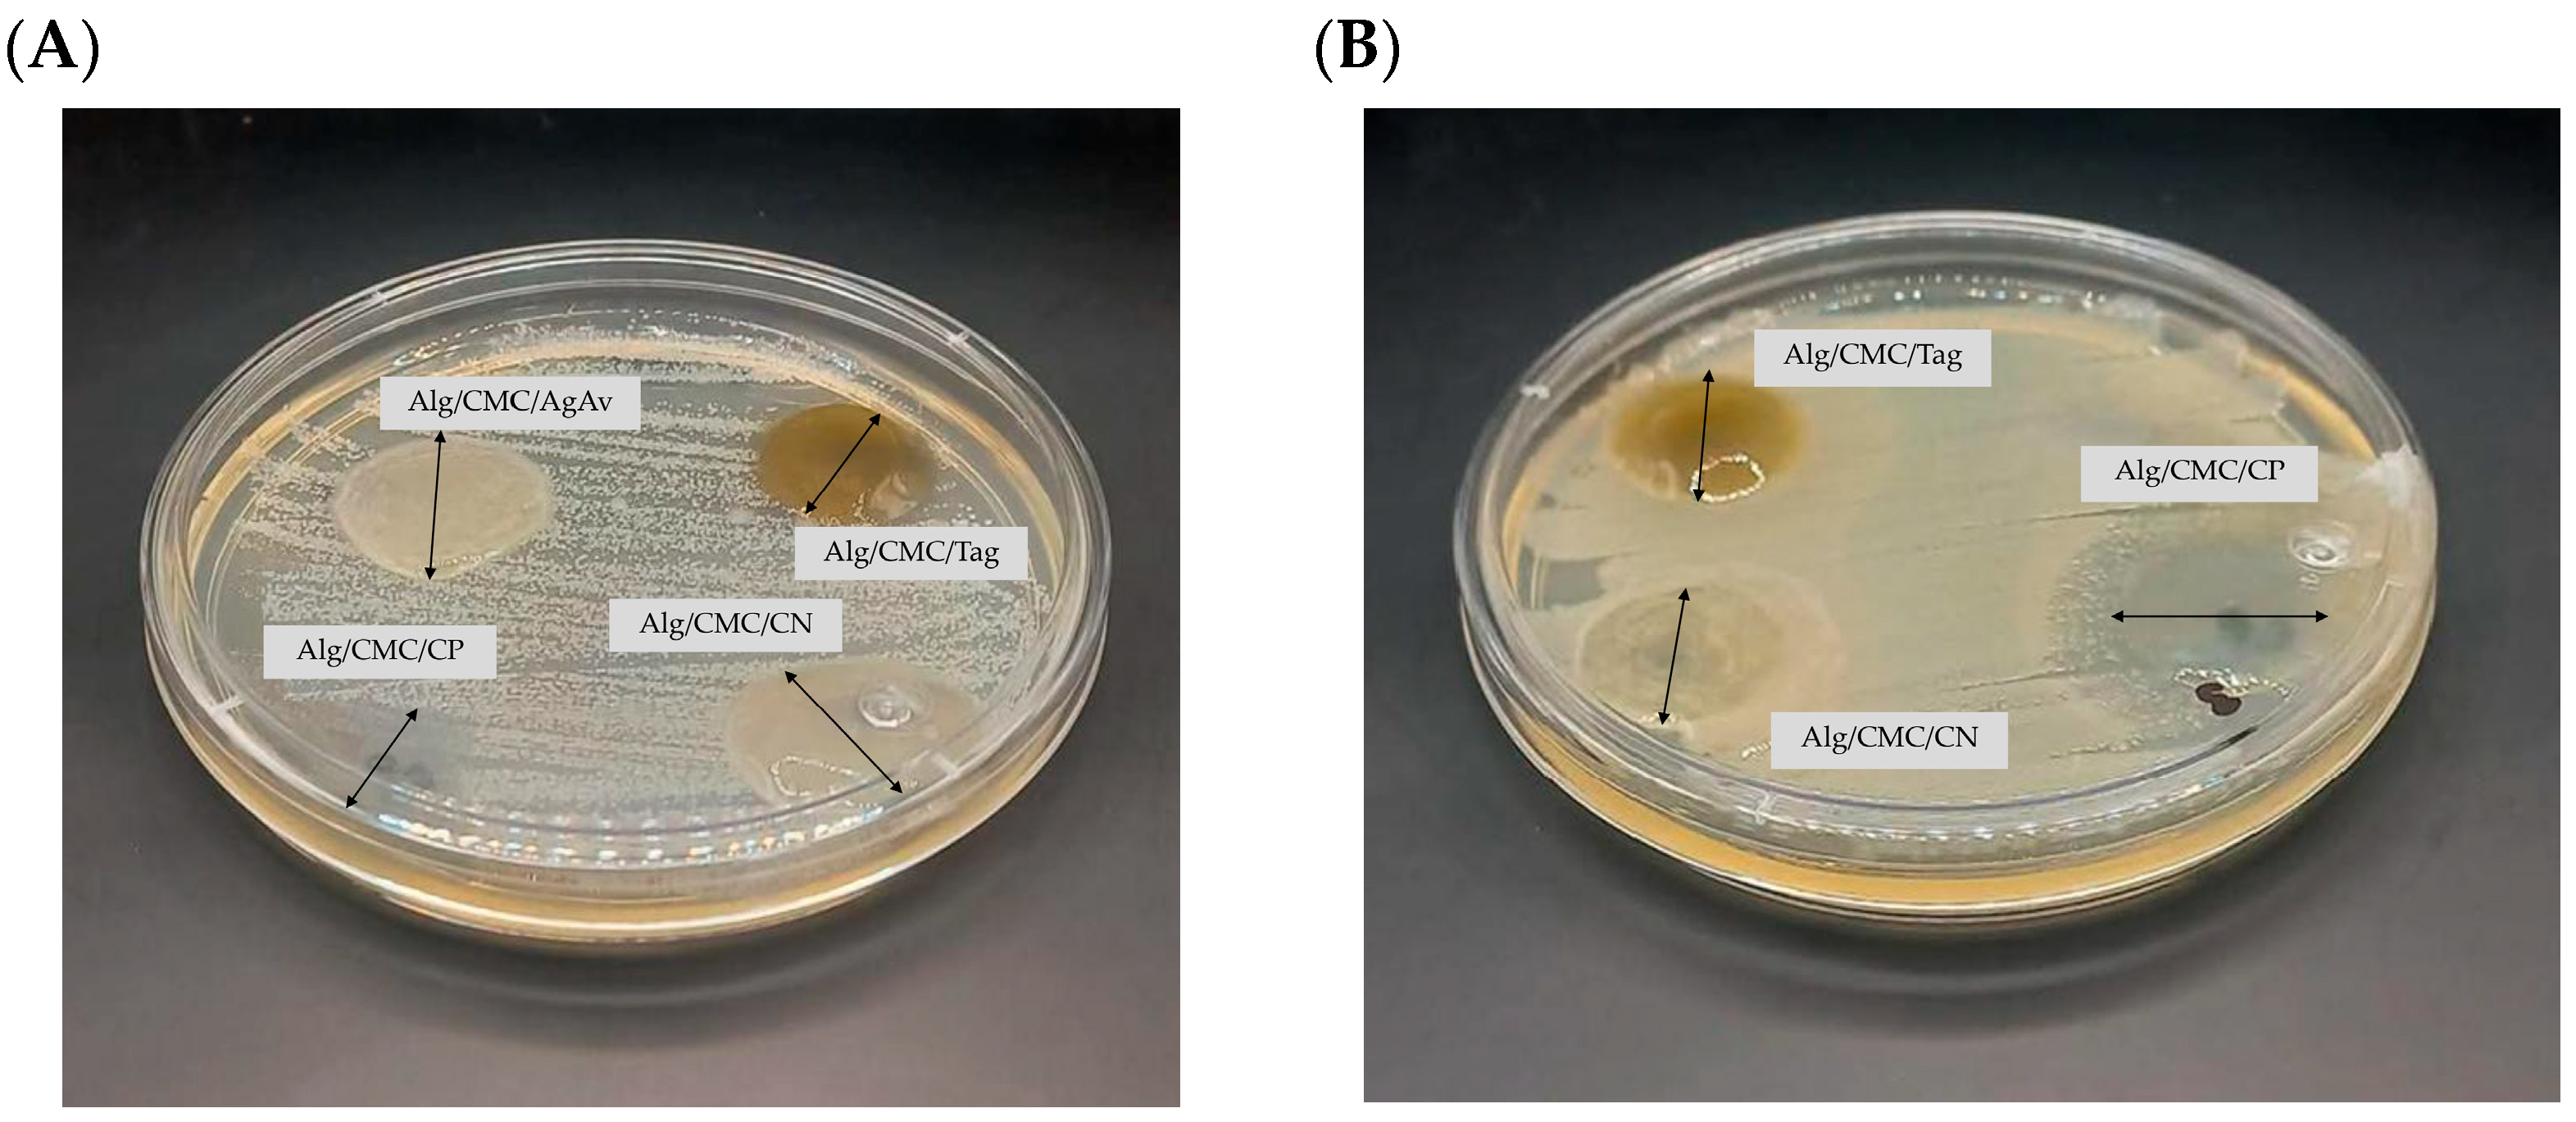

Characterization of Carboxymethylcellulose and Alginate-Based Dressings Incorporated with Plant Extract
Abstract
1. Introduction
2. Materials and Methods
2.1. Materials
2.2. Preparation of Plant Extracts
2.3. DPPH• Free Radical Scavenging
2.4. ABTS•+ Radical Scavenging
2.5. Ferric Ion Reducing Antioxidant Power (FRAP)
2.6. Preparation of Alg and CMC Dressings
2.7. Preparation of Alg/CMC/Extract Dressings
2.8. Physical Characterization of Dressings
2.8.1. Thickness
2.8.2. Scanning Electron Microscopy (SEM)
2.8.3. Moisture Vapor Transmission Rate (MVTR)
2.8.4. Light Transmission and Opacity
2.8.5. Water Absorption
2.8.6. Swelling
2.9. Mechanical Characterization of Dressings
2.10. Antibacterial Activity of Wound Dressings with Extract
2.11. Wound Healing In Vitro
- Group I: Mice treated with base gel (negative control)
- Group II: Mice treated with T. nelsonii extract in gel (100 mg/kg)
2.12. Statistical Analysis
3. Results
3.1. Antioxidant Capacity of the Extracts
3.2. Physical Characterization of Dressings
3.3. Characterization of Dressings with Extract
3.4. Antibacterial Activity of Dressings with Extract
3.5. Wound Healing In Vivo
4. Discussion
4.1. Antioxidant Capacity of the Extracts
4.2. Physical Characterization of Dressings
4.3. Characterization of Dressings with Extract and Antibacterial Activity
4.4. Wound Healing In Vivo
5. Conclusions
Author Contributions
Funding
Institutional Review Board Statement
Data Availability Statement
Conflicts of Interest
References
- Wang, Y.; Ma, Y.; Jiang, Z.; Hu, H.; Wang, S.; Chi, J.; Qiao, J.; Zhang, W.; Wang, Z.; Liu, W.; et al. Multifunctional effects of wound dressing based on chitosan-coordinated argentum with resistant bacterial penetration. Carbohydr. Polym. 2022, 288, 119329. [Google Scholar] [CrossRef]
- Brumberg, V.; Astrelina, T.; Malivanova, T.; Samoilov, A. Modern Wound Dressings: Hydrogel Dressings. Biomedicines 2021, 9, 1235. [Google Scholar] [CrossRef]
- Leyva-Gómez, G.; González-Torres, M.; Alcalá-Alcalá, S.; Bernal-Chávez, S.A.; Morales-Morfin, J.C.; González-Del Carmen, M.; Sharifi-Rad, J.; Figueroa-González, G.; Reyes-Hernández, O.D.; Del Prado-Audelo, M.L.; et al. Development of films from natural sources for infections during wound healing. Cell. Mol. Biol. 2021, 67, 96–100. [Google Scholar] [CrossRef] [PubMed]
- Balderas-Cordero, D.; Canales-Alvarez, O.; Sánchez-Sánchez, R.; Cabrera-Wrooman, A.; Canales-Martinez, M.M.; Rodriguez-Monroy, M.A. Anti-Inflammatory and Histological Analysis of Skin Wound Healing through Topical Application of Mexican Propolis. Int. J. Mol. Sci. 2023, 24, 11831. [Google Scholar] [CrossRef]
- Gounden, V.; Singh, M. Hydrogels and Wound Healing: Current and Future Prospects. Gels 2024, 10, 43. [Google Scholar] [CrossRef]
- Moeini, A.; Pedram, P.; Makvandi, P.; Malinconico, M.; Gomez d’Ayala, G. Wound healing and antimicrobial effect of active secondary metabolites in chitosan-based wound dressings: A review. Carbohydr. Polym. 2020, 233, 115839. [Google Scholar] [CrossRef]
- Xie, H.; Chen, X.; Shen, X.; He, Y.; Chen, W.; Luo, Q.; Ge, W.; Yuan, W.; Tang, X.; Hou, D.; et al. Preparation of chitosan-collagen-alginate composite dressing and its promoting effects on wound healing. Int. J. Biol. Macromol. 2018, 107, 93–104. [Google Scholar] [CrossRef] [PubMed]
- Barbu, A.; Neamtu, B.; Zăhan, M.; Iancu, G.M.; Bacila, C.; Mireșan, V. Current Trends in Advanced Alginate-Based Wound Dressings for Chronic Wounds. J. Pers. Med. 2021, 11, 890. [Google Scholar] [CrossRef] [PubMed]
- Elangwe, C.N.; Morozkina, S.N.; Olekhnovich, R.O.; Krasichkov, A.; Poliakova, V.O.; Uspenskaya, M.V. A Review on Chitosan and Cellulose Hydrogels for Wound Dressings. Polymers 2022, 14, 5163. [Google Scholar] [CrossRef]
- Montaser, A.S.; Jlassi, K.; Ramadan, M.A.; Sleem, A.A.; Attia, M.F. Alginate, gelatin, and carboxymethyl cellulose coated nonwoven fabrics containing antimicrobial AgNPs for skin wound healing in rats. Int. J. Biol. Macromol. 2021, 173, 203–210. [Google Scholar] [CrossRef]
- Massarelli, E.; Silva, D.; Pimenta, A.F.R.; Fernandes, A.I.; Mata, J.L.G.; Armês, H.; Salema-Oom, M.; Saramago, B.; Serro, A.P. Polyvinyl alcohol/chitosan wound dressings loaded with antiseptics. Int. J. Pharm. 2020, 593, 120110. [Google Scholar] [CrossRef] [PubMed]
- Zhang, M.; Zhao, X. Alginate hydrogel dressings for advanced wound management. Int. J. Biol. Macromol. 2020, 162, 1414–1428. [Google Scholar] [CrossRef] [PubMed]
- Kanikireddy, V.; Varaprasad, K.; Jayaramudu, T.; Karthikeyan, C.; Sadiku, R. Carboxymethyl cellulose-based materials for infection control and wound healing: A review. Int. J. Biol. Macromol. 2020, 164, 963–975. [Google Scholar] [CrossRef]
- Isopencu, G.; Deleanu, I.; Busuioc, C.; Oprea, O.; Surdu, V.-A.; Bacalum, M.; Stoica, R.; Stoica-Guzun, A. Bacterial Cellulose—Carboxymethylcellulose Composite Loaded with Turmeric Extract for Antimicrobial Wound Dressing Applications. Int. J. Mol. Sci. 2023, 24, 1719. [Google Scholar] [CrossRef]
- Gheorghita, R.; Filip, R.; Lupaescu, A.-V.; Iavorschi, M.; Anchidin-Norocel, L.; Gutt, G. Innovative Materials with Possible Applications in the Wound Dressings Field: Alginate-Based Films with Moringa oleifera Extract. Gels 2023, 9, 560. [Google Scholar] [CrossRef]
- Pelin, I.M.; Silion, M.; Popescu, I.; Rîmbu, C.M.; Fundueanu, G.; Constantin, M. Pullulan/Poly(vinyl alcohol) Hydrogels Loaded with Calendula officinalis Extract: Design and In Vitro Evaluation for Wound Healing Applications. Pharmaceutics 2023, 15, 1674. [Google Scholar] [CrossRef]
- De La Cruz-Jiménez, L.; Hernández-Torres, M.A.; Monroy-García, I.N.; Rivas-Morales, C.; Verde-Star, M.J.; Gonzalez-Villasana, V.; Viveros-Valdez, E. Biological Activities of Seven Medicinal Plants Used in Chiapas, Mexico. Plants 2022, 11, 1790. [Google Scholar] [CrossRef] [PubMed]
- Espinoza, R.M.; Palomeque, R.M.A.; Salazar, S.I.; Domínguez, A.S.; Canseco, A.L.M. Análisis preliminar de la actividad antimicrobiana de la planta medicinal Chik chawa (Tagetes nelsonii Greenm.). Rev. Cuba. Plantas Med. 2009, 14, 4. [Google Scholar]
- Bialik-Wąs, K.; Pluta, K.; Malina, D.; Barczewski, M.; Malarz, K.; Mrozek-Wilczkiewicz, A. Advanced SA/PVA-based hydrogel matrices with prolonged release of Aloe vera as promising wound dressings. Mater. Sci. Eng. C 2021, 120, 111667. [Google Scholar] [CrossRef]
- Olán-Jiménez, K.A.; Cruz-Rodríguez, R.I.; Couder-García, B.d.C.; Jacobo-Herrera, N.; Ruiz-Lau, N.; Hernández-Cruz, M.d.C.; Ruíz-Valdiviezo, V.M. Antibacterial and Wound Healing Activity In Vitro of Individual and Combined Extracts of Tagetes nelsonii Greenm, Agave americana and Aloe vera. Sci. Pharm. 2024, 92, 41. [Google Scholar] [CrossRef]
- Castañeda-Valbuena, D.; Ayora-Talavera, T.; Luján-Hidalgo, C.; Álvarez-Gutiérrez, P.; Martínez-Galero, N.; Meza-Gordillo, R. Ultrasound extraction conditions effect on antioxidant capacity of mango by-product extracts. Food Bioprod. Process 2021, 127, 212–224. [Google Scholar] [CrossRef]
- Zhou, T.; Xu, D.-P.; Lin, S.-J.; Li, Y.; Zheng, J.; Zhou, Y.; Zhang, J.-J.; Li, H.-B. Ultrasound-Assisted Extraction and Identification of Natural Antioxidants from the Fruit of Melastoma sanguineum Sims. Molecules 2017, 22, 306. [Google Scholar] [CrossRef] [PubMed]
- Arab, M.; Jallab, M.; Ghaffari, M.; Moghbelli, E.; Saeb, M.R. Synthesis, rheological characterization, and antibacterial activity of polyvinyl alcohol (PVA)/zinc oxide nanoparticles wound dressing, achieved under electron beam irradiation. Iran. Polym. J. 2021, 30, 1019–1028. [Google Scholar] [CrossRef]
- Garcia-Orue, I.; Santos-Vizcaino, E.; Sanchez, P.; Gutierrez, F.B.; Aguirre, J.J.; Hernandez, R.M.; Igartua, M. Bioactive and degradable hydrogel based on human platelet-rich plasma fibrin matrix combined with oxidized alginate in a diabetic mice wound healing model. Mater. Sci. Eng. C Mater. Biol. Appl. 2022, 135, 112695. [Google Scholar] [CrossRef]
- Mirmajidi, T.; Chogan, F.; Rezayan, A.H.; Sharifi, A.M. In vitro and in vivo evaluation of a nanofiber wound dressing loaded with melatonin. Int. J. Pharm. 2021, 596, 120213. [Google Scholar] [CrossRef]
- Venkatesan, K.; Sivadasan, D.; Abderrahmen Al Weslati, M.; Gayasuddin Mouid, M.; Goyal, M.; Bansal, M.; Salama, M.E.-D.M.; Azizullah Ghori, S.; Ahmad, F. Protective Effects of Frankincense Oil on Wound Healing: Downregulating Caspase-3 Expression to Facilitate the Transition from the Inflammatory to Proliferative Phase. Pharmaceuticals 2025, 18, 816. [Google Scholar] [CrossRef]
- Burlec, A.F.; Pecio, L.; Kozachok, S.; Mircea, C.; Corciovă, A.; Vereștiuc, L.; Cioancă, O.; Oleszek, W.; Hăncianu, M. Phytochemical Profile, Antioxidant Activity, and Cytotoxicity Assessment of Tagetes erecta Flowers. Molecules 2021, 26, 1201. [Google Scholar] [CrossRef] [PubMed]
- Lopez, V.; Dueñas, R.A.A.; Cuenca, N.J.G.; Rodríguez, D.J.M. Caracterización fitoquímica, actividad antioxidante y antibacteriana del aceite esencial y extractos de Tagetes patula sobre Staphylococcus aureus. Rev. Tec. Fac. Ing. Univ. Zulia 2020, 37, 347–367. [Google Scholar] [CrossRef]
- Aati, H.Y.; Emam, M.; Al-Qahtani, J.; Aati, S.; Aati, A.; Wanner, J.; Seif, M.M. Chemical Composition of Tagetes patula Flowers Essential Oil and Hepato-Therapeutic Effect against Carbon Tetrachloride-Induced Toxicity (In-Vivo). Molecules 2022, 27, 7242. [Google Scholar] [CrossRef]
- Wang, G.; Yang, F.; Zhou, W.; Xiao, N.; Luo, M.; Tang, Z. The initiation of oxidative stress and therapeutic strategies in wound healing. Biomed. Pharmacother. 2023, 157, 114004. [Google Scholar] [CrossRef]
- Kuddushi, M.; Shah, A.A.; Ayranci, C.; Zhang, X. Recent advances in novel materials and techniques for developing transparent wound dressings. J. Mater. Chem. B 2023, 11, 6201–6224. [Google Scholar] [CrossRef]
- Ahmad, N. In Vitro and In Vivo Characterization Methods for Evaluation of Modern Wound Dressings. Pharmaceutics 2022, 15, 42. [Google Scholar] [CrossRef]
- Archana, D.; Dutta, J.; Dutta, P.K. Evaluation of chitosan nano dressing for wound healing: Characterization, in vitro and in vivo studies. Int. J. Biol. Macromol. 2013, 57, 193–203. [Google Scholar] [CrossRef]
- Trevisol, T.C.; Fritz, A.R.M.; de Souza, S.M.A.G.U.; Bierhalz, A.C.K.; Valle, J.A.B. Alginate and carboxymethyl cellulose in monolayer and bilayer films as wound dressings: Effect of the polymer ratio. J. Appl. Polym. Sci. 2018, 136, 46941. [Google Scholar] [CrossRef]
- Brás, T.; Rosa, D.; Gonçalves, A.C.; Gomes, A.C.; Alves, V.D.; Crespo, J.G.; Duarte, M.F.; Neves, L.A. Development of bioactive films based on chitosan and Cynara cardunculus leaves extracts for wound dressings. Int. J. Biol. Macromol. 2020, 163, 1707–1718. [Google Scholar] [CrossRef]
- Karoyo, A.H.; Wilson, L.D. A Review on the Design and Hydration Properties of Natural Polymer-Based Hydrogels. Materials 2021, 14, 1095. [Google Scholar] [CrossRef]
- Kordjazi, S.; Kamyab, K.; Hemmatinejad, N. Super-hydrophilic/oleophobic chitosan/acrylamide hydrogel: An efficient water/oil separation filter. Adv. Compos. Hybrid. Mater. 2020, 3, 167–176. [Google Scholar] [CrossRef]
- Khan, M.U.A.; Iqbal, I.; Ansari, M.N.M.; Razak, S.I.A.; Raza, M.A.; Sajjad, A.; Jabeen, F.; Riduan Mohamad, M.; Jusoh, N. Development of Antibacterial, Degradable and pH-Responsive Chitosan/Guar Gum/Polyvinyl Alcohol Blended Hydrogels for Wound Dressing. Molecules 2021, 26, 5937. [Google Scholar] [CrossRef] [PubMed]
- Shahzad, A.; Khan, A.; Afzal, Z.; Umer, M.F.; Khan, J.; Khan, G.M. Formulation development and characterization of cefazolin nanoparticles-loaded cross-linked films of sodium alginate and pectin as wound dressings. Int. J. Biol. Macromol. 2019, 124, 255–269. [Google Scholar] [CrossRef] [PubMed]
- Sanchez-Salvador, J.L.; Balea, A.; Concepcion, M.M.; Negro, C.; Blanco, A. Chitosan grafted/cross-linked with biodegradable polymers: A review. Int. J. Biol. Macromol. 2021, 178, 325–343. [Google Scholar] [CrossRef] [PubMed]
- Russo, R.; Malinconico, M.; Santagata, G. Effect of cross-linking with calcium ions on the physical properties of alginate films. Biomacromolecules 2007, 8, 3193–3197. [Google Scholar] [CrossRef] [PubMed]
- Straccia, M.C.; Romano, I.; Oliva, A.; Santagata, G.; Laurienzo, P. Crosslinker effects on functional properties of alginate/N-succinylchitosan based hydrogels. Carbohydr. Polym. 2014, 108, 321–330. [Google Scholar] [CrossRef] [PubMed]
- Baukum, J.; Pranjan, J.; Kaolaor, A.; Chuysinuan, P.; Suwantong, O.; Supaphol, P. The potential use of cross-linked alginate/gelatin hydrogels containing silver nanoparticles for wound dressing applications. Polym. Bull. 2020, 77, 2679–2695. [Google Scholar] [CrossRef]
- Li, L.; Zhao, J.; Yiran, S.; Yu, F.; Ma, J. Ionically Cross-linked Sodium Alginate/ĸ-Carrageenan Double-Network Gel Beads with Low-swelling, Enhanced Mechanical Properties, and Excellent Adsorption Performance. Chem. Eng. J. 2019, 372, 1091–1103. [Google Scholar] [CrossRef]
- Jantrawut, P.; Bunrueangtha, J.; Suerthong, J.; Kantrong, N. Fabrication and Characterization of Low Methoxyl Pectin/Gelatin/Carboxymethyl Cellulose Absorbent Hydrogel Film for Wound Dressing Applications. Materials 2019, 12, 1628. [Google Scholar] [CrossRef]
- Rahmani, H.; Najafi, S.H.M.; Ashori, A.; Fashapoyeh, M.A.; Mohseni, F.A.; Torkaman, S. Preparation of chitosan-based composites with urethane cross linkage and evaluation of their properties for using as wound healing dressing. Carbohydr. Polym. 2020, 230, 115606. [Google Scholar] [CrossRef] [PubMed]
- Hu, D.Q.; Qiang, T.; Wang, L. Quaternized chitosan/polyvinyl alcohol/sodium carboxymethylcellulose blend application. Wound Med. 2017, 16, 15–21. [Google Scholar] [CrossRef]
- Khodabakhshi, D.; Eskandarinia, A.; Kefayat, A.; Rafienia, M.; Navid, S.; Karbasi, S.; Moshtaghian, J. In vitro and in vivo performance of a propolis-coated polyurethane wound dressing with high porosity and antibacterial efficacy. Colloids Surf. B 2019, 178, 177–184. [Google Scholar] [CrossRef]
- Almasian, A.; Najafi, F.; Eftekhari, M.; Ardekani, M.R.; Sharifzadeh, M.; Khanavi, M. Polyurethane/carboxymethylcellulose nanofibers containing Malva sylvestris extract for healing diabetic wounds: Preparation, characterization, in vitro and in vivo studies. Mater. Sci. Eng. C 2020, 114, 111039. [Google Scholar] [CrossRef]
- Hadizadeh, M.; Naeimi, M.; Rafienia, M.; Karkhaneh, A. A bifunctional electrospun nanocomposite wound dressing containing surfactin and curcumin: In vitro and in vivo studies. Mater. Sci. Eng. C 2021, 129, 112362. [Google Scholar] [CrossRef]
- Thomas, D.; Nath, M.S.; Mathew, N.; Reshmy, R.; Philip, E.; Latha, M.S. Alginate Film Modified with Aloe vera Gel and Cellulose Nanocrystals for Wound Dressing Application: Preparation, Characterization and In vitro Evaluation. J. Drug Deliv. Sci. Technol. 2020, 59, 101894. [Google Scholar] [CrossRef]
- Balakrishnan, B.; Mohanty, M.; Umashankar, P.R.; Jayakrishnan, A. Evaluation of an in situ forming hydrogel wound dressing based on oxidized alginate and gelatin. Biomaterials 2005, 26, 6335–6342. [Google Scholar] [CrossRef]
- Zhou, G.; Ruhan, A.; Ge, H.; Wang, L.; Liu, M.; Wang, B.; Su, H.; Yan, M.; Xi, Y.; Fan, F. Research on a novel poly (vinyl alcohol)/lysine/vanillin wound dressing: Biocompatibility, bioactivity and antimicrobial activity. Burns 2014, 40, 1668–1678. [Google Scholar] [CrossRef]
- Valor, D.; Montes, A.; García-Casas, I.; Pereyra, C.; Martínez de la Ossa, E.J. Supercritical solvent impregnation of alginate wound dressings with mango leaves extract. J. Supercrit. Fluids 2021, 178, 105357. [Google Scholar] [CrossRef]
- Bajpai, S. Biological importance of Aloe vera and its active constituents. In Synthesis of Medicinal Agents from Plants; Elsevier: Amsterdam, The Netherlands, 2018; pp. 177–203. [Google Scholar] [CrossRef]
- Ningrum, D.R.; Hanif, W.; Mardhian, D.F.; Asri, L.A.T.W. In Vitro Biocompatibility of Hydrogel Polyvinyl Alcohol/Moringa oleifera Leaf Extract/Graphene Oxide for Wound Dressing. Polymers 2023, 15, 468. [Google Scholar] [CrossRef] [PubMed]
- Wichai, S.; Chuysinuan, P.; Chaiarwut, S.; Ekabutr, P.; Supaphol, P. Development of bacterial cellulose/alginate/chitosan composites incorporating copper (II) sulfate as an antibacterial wound dressing. J. Drug Deliv. Sci. Technol. 2019, 51, 662–671. [Google Scholar] [CrossRef]
- Ramos, M.; Valdés, A.; Beltrán, A.; Garrigós, M.C. Gelatin-Based Films and Coatings for Food Packaging Applications. Coatings 2016, 6, 41. [Google Scholar] [CrossRef]
- Edwards, C.; Marks, R. Evaluation of biomechanical properties of human skin. Clin. Dermatol. 1995, 13, 375–380. [Google Scholar] [CrossRef] [PubMed]
- Bayer, G.; Shayganpour, A.; Bayer, I.S. Antioxidant activity of limonene modified cellulose pulp fiber-polylactic acid (PLA) composites. Cellulose 2023, 30, 1599–1622. [Google Scholar] [CrossRef]
- Marchese, A.; Barbieri, R.; Coppo, E.; Orhan, I.E.; Daglia, M.; Nabavi, S.F.; Izadi, M.; Abdollahi, M.; Nabavi, S.M.; Ajami, M. Antimicrobial activity of eugenol and essential oils containing eugenol: A mechanistic viewpoint. Crit. Rev. Microbiol. 2017, 43, 668–689. [Google Scholar] [CrossRef]
- Yarkent, Ç.; Oncel, S.S. Recent Progress in Microalgal Squalene Production and Its Cosmetic Application. Biotechnol. Bioprocess Eng. 2022, 7, 295–305. [Google Scholar] [CrossRef]
- Ndlovu, S.P.; Motaung, S.C.M.; Adeyemi, S.A.; Ubanako, P.; Ngema, L.M.; Fonkui, T.Y.; Aderibigbe, B.A. Sodium alginate/carboxymethylcellulose gel formulations containing Capparis sepieria plant extract for wound healing. Ther. Deliv. 2024, 15, 921–937. [Google Scholar] [CrossRef]
- Kamel, S.; Dacrory, S.; Hesemann, P.; Bettache, N.; Ali, L.M.A.; Postel, L.; Akl, E.M.; El-Sakhawy, M. Wound Dressings Based on Sodium Alginate–Polyvinyl Alcohol–Moringa oleifera Extracts. Pharmaceutics 2023, 15, 1270. [Google Scholar] [CrossRef] [PubMed]
- Balaji Ayyanar, C.; Bal, T.; Fahaduddin; Sharma, S.; Gayathri, B.; Rinusuba, V.; Esther Nalini, H.; Deepa, S.; Dhivyya Dharshinii, M.; Kharra, P.; et al. In-vitro and in-vivo investigation of wound healing efficacy of Syzygium cumini leaf extracts loaded carboxymethylcellulose film. Int. J. Biol. Macromol. 2024, 275, 133691. [Google Scholar] [CrossRef]
- Bâldea, I.; Soran, M.-L.; Stegarescu, A.; Opriș, O.; Kacso, I.; Tripon, S.; Adascalitei, A.; Fericel, I.G.; Decea, R.; Lung, I. Lilium candidum Extract Loaded in Alginate Hydrogel Beads for Chronic Wound Healing. Gels 2025, 11, 22. [Google Scholar] [CrossRef] [PubMed]

| Treatment | Alg (% w/v) | CMC (% w/v) | Glycerol (% v/v) | CaCl2 (M) | Active Component (AC) | Concentration AC * (mg/mL) |
|---|---|---|---|---|---|---|
| Alg/CMC/Tag | 2 | 1.5 | 10 | 0.45 | T. nelsonii | 25 |
| Alg/CMC/AgAv | 2 | 1.5 | 10 | 0.45 | A. americana + A. vera gel | 25/30 ** |
| Alg/CMC/CP | 2 | 1.5 | 10 | 0.45 | Chloramphenicol | 0.256 |
| Alg/CMC/CN | 2 | 1.5 | 10 | 0.45 | - | - |
| Extract | DPPH | ABTS | FRAP |
|---|---|---|---|
| T. nelsonii | 11.238 ± 0.033 a | 8.624 ± 0.368 a | 16.283 ± 0.299 a |
| A. americana | 0.589 ± 0.012 b | 0.596 ± 0.012 b | 0.806 ± 0.020 b |
| A. vera | 0.011 ± 0.001 c | 0.041 ± 0.015 c | 0.013 ± 0.003 c |
| Treatment | CaCl2 (%) | TN (mm) | OP (%) | TR (%) | WA (%) | SW (%) | TS (N/mm2) | EB (%) |
|---|---|---|---|---|---|---|---|---|
| A | 1 | 0.936 a | 0.41 c | 41.714 c | 34.969 c | 56.428 b | 0.442 a | 79.226 c |
| B | 3 | 0.891 a | 0.29 b | 53.703 b | 53.778 b | 81.38 a | 0.338 b | 97.544 b |
| C | 5 | 0.996 a | 0.13 a | 74.711 a | 72.915 a | 92.03 a | 0.248 c | 167.696 a |
| Tukey | 0.082 | 0.051 | 6.912 | 13.975 | 16.309 | 0.054 | 14.794 |
| Dressing | TN (mm) | OP (%) | TR (%) | MVTR (g/m2d) | WA (%) | SW (%) | TS (N/mm2) | EB (%) |
|---|---|---|---|---|---|---|---|---|
| Alg/CMC/Tag | 1.022 a | 0.85 c | 14.928 d | 395.167 ab | 156.934 a | 127.869 a | 0.506 a | 395.167 ab |
| Alg/CMC/AgAv | 0.902 ab | 0.43 ab | 40.676 b | 320.859 b | 106.064 b | 125.148 b | 0.460 ab | 320.859 b |
| Alg/CMC/CP | 0.963 ab | 0.53 b | 30.555 c | 330.309 ab | 84.009 bc | 124.703 bc | 0.363 bc | 330.309 ab |
| Alg/CMC/CN | 0.981 b | 0.28 a | 52.62 a | 421.691 a | 79.583 c | 98.371 c | 0.266 c | 421.691 a |
| Tukey | 0.091 | 0.172 | 5.445 | 98.626 | 17.780 | 21.763 | 0.113 | 10.161 |
| Bacteria | Alg/CMC/Tag | Alg/CMC/AgAv | Alg/CMC/CP | Alg/CMC/CN |
|---|---|---|---|---|
| Inhibition Zone (mm) | ||||
| S. aureus | 19.333 a | 0 c | 19.666 a | 0 c |
| P. aeruginosa | 17.733 b | 0 c | 18.033 a | 0 c |
| Type of Wound Dressing | Extract | Antibacterial Activity | Wound Healing Activity | Advantages | Disadvantages | References |
|---|---|---|---|---|---|---|
| Alg-CMC | Aqueous extract of Capparis sepieria | Strong against Gram-positive and negative | Stimulates fibroblast migration and proliferation | Suitable for burns; good cell viability | No in vivo animal testing | [63] |
| BC *-CMC * | Curcumin | Moderate (E. coli, S. aureus) | Antioxidant, promotes cell viability | Dual antioxidant and antibacterial activity | Only in vitro characterization; lacks in vivo testing | [14] |
| Alg *-PVA * hydrogel | Moringa oleifera extract | Antibacterial vs S. aureus, E. faecalis, E. coli | Promototed granulation and ephitelialization un mouse wound model | Good biocompatibility, swelling, moisture retention | Lacks testing vs other strains, limited mechanical/degradation data | [64] |
| Alg-films based on sodium alginate | Moringa oleifera powder/essential oil (10–30%) | Not analyzed | Suggested for wound types; high swelling/moisture retention | Homogeneous matrix, prolonged release, TS ≈ 0.248 MPa, elongation ≈ 31%, 4800% swelling | No in vivo data; antimicrobial not strain-specific; no degradation analysis | [15] |
| CMC | Leaf extract of Syzygium cumini | Inhibition zones: S. aureus (15 mm) E. coli (11 mm) | 83% wound closure L929 cell line full healing in 7 days (in vivo) | Antioxidant activity (63%) | No long-term mechanical/stability data; needs broader validation | [65] |
| Pullulan/PVA hydrogel | Calendula officinalis extract | Inhibition zones: S. aureus (13 mm) P. aeruginosa (15 mm) | 70% DPPH antioxidant activity | High loading bioadhesiveness; tunable swelling and mechanics | No in vivo data; decreased mechanical strength at higher loading; cytotoxicity at high dose | [16] |
| Alginate hydrogel | Leaf extract of Lilium candidum | Not quantified | Promotes fibroblast and endothelial migration; better wound closure and scar formation than extract or hydrogel alone (in vitro) | Antioxidant, anti-inflammatory, cell migration support | No antimicrobial quantification | [66] |
Disclaimer/Publisher’s Note: The statements, opinions and data contained in all publications are solely those of the individual author(s) and contributor(s) and not of MDPI and/or the editor(s). MDPI and/or the editor(s) disclaim responsibility for any injury to people or property resulting from any ideas, methods, instructions or products referred to in the content. |
© 2025 by the authors. Licensee MDPI, Basel, Switzerland. This article is an open access article distributed under the terms and conditions of the Creative Commons Attribution (CC BY) license (https://creativecommons.org/licenses/by/4.0/).
Share and Cite
Olán-Jiménez, K.A.; Cruz-Rodríguez, R.I.; Couder-García, B.d.C.; Jacobo-Herrera, N.; Ruiz-Lau, N.; Hernández-Cruz, M.d.C.; Ayora-Talavera, T.; Briones-Aranda, A. Characterization of Carboxymethylcellulose and Alginate-Based Dressings Incorporated with Plant Extract. Polysaccharides 2025, 6, 75. https://doi.org/10.3390/polysaccharides6030075
Olán-Jiménez KA, Cruz-Rodríguez RI, Couder-García BdC, Jacobo-Herrera N, Ruiz-Lau N, Hernández-Cruz MdC, Ayora-Talavera T, Briones-Aranda A. Characterization of Carboxymethylcellulose and Alginate-Based Dressings Incorporated with Plant Extract. Polysaccharides. 2025; 6(3):75. https://doi.org/10.3390/polysaccharides6030075
Chicago/Turabian StyleOlán-Jiménez, Karen Alejandra, Rosa Isela Cruz-Rodríguez, Beatriz del Carmen Couder-García, Nadia Jacobo-Herrera, Nancy Ruiz-Lau, Maritza del Carmen Hernández-Cruz, Teresa Ayora-Talavera, and Alfredo Briones-Aranda. 2025. "Characterization of Carboxymethylcellulose and Alginate-Based Dressings Incorporated with Plant Extract" Polysaccharides 6, no. 3: 75. https://doi.org/10.3390/polysaccharides6030075
APA StyleOlán-Jiménez, K. A., Cruz-Rodríguez, R. I., Couder-García, B. d. C., Jacobo-Herrera, N., Ruiz-Lau, N., Hernández-Cruz, M. d. C., Ayora-Talavera, T., & Briones-Aranda, A. (2025). Characterization of Carboxymethylcellulose and Alginate-Based Dressings Incorporated with Plant Extract. Polysaccharides, 6(3), 75. https://doi.org/10.3390/polysaccharides6030075

